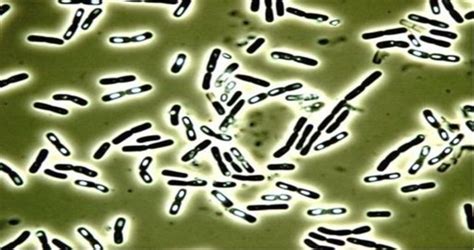
Ilustrácia baktérie Bacillus cereus

V dnešnej dobe má málokto čas variť jedlo každý deň. Preto sa stáva, že odpočíva na kredenci dlhšie ako 2 dni. Hoci srdce na vyhadzovanie jedla nemáte, dáte si ho aj niekoľko dní po uvarení. Čo však na to povie váš organizmus?
Ak necháte mäso na kredenci tri dni, už ho nezachránite. To isté však platí aj o inom jedle! Aj nevinne vyzerajúca ryža a cestoviny by sa nemali dávať na tanier niekoľko dní po uvarení. Po takomto čase sa v nich začne vytvárať baktéria Bacillus cereus, ako sa uvádza na sciencealert.com. Nielenže sa táto baktéria nachádza v pôde, v prachových časticiach či v rastlinách, vyskytuje sa aj na miestach, kde má prístup k dostatku živín z jedla, teda na ryži, korení, zelenine, atď.
Zaujímavé je, že má rôzne formy. Niektoré účinkujú ako probiotiká, iné zase môžu vyvolať príznaky otravy jedlom.
Prípady otravy jedlom
O tom, že otrava kvôli niekoľkodňovému starému jedlu nie je nezmysel, svedčí správa v časopise Journal of Clinical Microbiology z roku 2005. Päť detí v domácnosti sa otrávili po tom, ako zjedli 4 dni starý cestovinový šalát. Ten bol pripravený v piatok, v sobotu si ho rodina vzala na piknik a do pondelka odpočíval v chladničke, kedy ho deti zjedli. U detí sa po zjedení cestovín objavili typické príznaky otravy jedlom. Podľa vedcov v štúdii prípady otravy jedlom zvyčajne nekončia na pohotovosti a ojedinelé sú úmrtia či trvalé poškodenia pečene. Avšak, nešlo o jediný prípad!
Ďalší prípad sa odohral v Belgicku v roku 2011, kedy si 20-ročný študent týždeň vopred pripravil jedlo. V predstihu si uvaril špagety, ktoré si ohrial spolu s omáčkou a nechal istý čas na kuchynskej linke. Keď zjedol cestoviny, nastúpila hnačka, bolesť brucha, zvracanie.
V posledných týždňoch sa na sociálnych sieťach znovu objavila správa z roku 2008, ktorá vydesila ľudí. Týka sa nebezpečenstva konzumácie zohriatych zvyškov škrobov, najmä tých, ktoré sa nachádzajú v ryži a cestovinách. V časopise Journal of Clinical Microbiology bol zverejnený prípad študenta z Bruselu, ktorý skonzumoval tanier špagiet päť dní po tom, čo ich uvaril. To údajne viedlo k jeho smrti. Išlo o otravu jedlom spôsobenú baktériou Bacillus cereus.
Expertka na bezpečnosť potravín Ellen Shumakerová ale prezradila, že organizmus zvyčajne chorobu nespôsobuje. Po uvarení môžu spóry vyklíčiť, aktivovať sa a začať vytvárať toxíny. "Spóry organizmu klíčia v reakcii na teplo pri varení," povedal profesor a špecialista v odbore potravinárstva Donald Schaffner. Organizmus prežije proces varenia a potom rýchlo rastie v potravinách, ktoré nie sú správne chladené.
Spóry vo všeobecnosti klíčia, keď jedlo necháte v "zóne teplotného nebezpečenstva", čo je teplota medzi štyrmi a 60 stupňami Celzia. Je dôležité si uvedomiť, že hoci sa proces klíčenia môže začať počas varenia, pokračuje, kým má jedlo izbovú teplotu. Po uvarení je jedlo zrelé na klíčenie spór, pokiaľ ho ihneď nevložíte do chladničky, čím by ste zastavili množenie aktívnych baktérií.
Veľa ľudí si myslí, že je nebezpečné, keď chladíte ešte teplé jedlo. Ukázalo sa však, že opak je pravdou. Keďže v zóne tepelného nebezpečenstva dochádza k tvorbe toxínov, je dôležité rýchlo ochladiť potraviny. Všetko ale závisí od veľkosti porcie, ktorú odkladáte. Presnejšie povedané, čím väčší hrniec, tým dlhšie bude trvať, kým jedlo v strede hrnca vychladne.
Vo všeobecnosti sú príznaky syndrómu vyprážanej ryže podobné tým, ktoré sa vyskytujú pri reakcii na iné typy otravy jedlom, čiže zvracanie, hnačka, nevoľnosť, kŕče v bruchu a podobne. Na rozdiel od iných baktérií, ktoré spôsobujú otravu takmer okamžite po konzumácii, však Bacillus cereus môže viesť k reakciám tridsať minút až päť hodín po požití.
Hoci pri syndróme neexistuje žiadny liek, ktorý by ste mali užívať, najdôležitejšie je dbať na hydratáciu. V závažných prípadoch, keď zvracanie a hnačka trvajú hodiny, je vhodné vyhľadať odborníka.
Baktéria Bacillus cereus
Baktéria Bacillus cereus nie je ničím výnimočná a vyskytuje sa prakticky všade - v pôde, v organizmoch zvierat a hmyzu, v prachových časticiach aj v rastlinách. B. cereus sa rozmnožuje najmä na miestach, kde má prístup k dostatku živín z jedla, teda aj na ryži, mliečnych výrobkoch, korení, sušenom jedle a zelenine. Niektoré formy baktérie účinkujú ako probiotiká, iné zas u človeka dokážu vyvolať príznaky otravy jedlom.
Baktéria je známa tým, že do jedla uvoľňuje nebezpečné toxíny. Jedným takýmto toxínom je emetický toxín, ktorý u človeka spôsobuje vracanie. Odolá teplu až do 121 stupňov Celzia po dobu 90 minút! Ďalším nebezpečným toxínom je hemolyzín BL, ktorý v tele vyvoláva zápal.
Biotechnologička z Austrálskej národnej univerzity Anukriti Mathurová dodnes pracuje na identifikovaní spôsobov, ako zastaviť ničivý hemolyzín. Vedecký tím sa zameriava na to, ako zastaviť aktivitu toxínu a ako znížiť zápal, ktorý vyvoláva. Kým vedci nenájdu spôsob, ako zabrániť postupu smrteľných toxínov v tele, stačí, keď si jedlo budete odkladať do chladničky a pred konzumáciou ho tepelne ošetríte.
B. cereus môže spôsobiť vážne a smrteľné stavy, ako je sepsa, u ľudí s oslabenou imunitou, dojčiat, starších a tehotných žien.
Ako predchádzať otrave z jedla
Mali by byť niekoľkodňové cestoviny skutočne pre nás tabu? Treba upozorniť, že uvedené prípady sú veľmi vzácne a nehrozia žiadne vážne zdravotné problémy.
Pred opätovnou konzumáciou prelejte cestoviny a ryžu vriacou vodou.
Ryžu a cestoviny po uvarení a vychladnutí schovajte do chladničky. Rýchlo sa na nich množí baktéria Bacillus cereus. Vyvolá zvracanie do 1 hodiny alebo hnačku do 8 až 16 hodín. Príznaky ustúpia do 24 hodín.
Základné pravidlá prevencie:
- Surové mäso krájajte vždy na jednej konkrétnej doske, ktorú nebudete používať na nič iné. Mala by byť drevená, pretože drevo má antibakteriálne vlastnosti. Vždy po použití ju dokradne umyte horúcou vodou a saponátom.
- Mäso majte v chladničke položené tak, aby z neho nemohlo nič kvapkať na hotové potraviny pod ním.
- Dôkladne si obzrite tovar, ktorý kupujete. Ak je to spracovaný mäsový alebo mliečny výrobok nesmie mať porušený obal.
- Nejedzte potraviny po záruke. Kontrolujte si dátumy spotreby.
- Ak si kupujete syr alebo nátierku v črievku, neotvárajte ju zubami, ak ste črievko neumyli.
- Otvorené výrobky, ktoré sa nedajú opätovne uzavrieť sú určené na priamu konzumáciu.
- Umývajte si ruky pred akoukoľvek manipuláciou s jedlom.
- Nejedzte jedlo z nafúknutej konzervy či pohára s nafúknutým viečkom alebo ak počujete unikať plyn pri jej otváraní.
Je dôležité, aby si ľudia správne umyli ruky a pripravovali potraviny podľa bezpečnostných pokynov.
Ako zistiť, či sú cestoviny ešte dobré?
- Zápach: Ak cestoviny zapáchajú kyslo, zatuchnuto alebo inak nepríjemne, vyhoďte ich.
- Vzhľad: Ak cestoviny vyzerajú slizko, majú zmenenú farbu alebo na nich vidíte pleseň, vyhoďte ich.
- Textúra: Ak sú cestoviny lepkavé alebo majú neobvyklú textúru, vyhoďte ich.
Ak máte akékoľvek pochybnosti o kvalite cestovín, je lepšie ich vyhodiť, ako riskovať zdravotné problémy.
Trvanlivosť a skladovanie uvarených cestovín
Otázka trvanlivosti cestovín v chladničke je bežná, no odpoveď na ňu nie je vždy jednoznačná. Množstvo faktorov ovplyvňuje, ako dlho si cestoviny zachovajú svoju kvalitu a bezpečnosť po uvarení a uskladnení v chladničke.
Faktory ovplyvňujúce trvanlivosť cestovín
- Typ cestovín: Čerstvé cestoviny sa líšia od sušených cestovín, a to ako v zložení, tak aj v trvanlivosti.
- Spôsob prípravy: Správne uvarenie a ochladenie cestovín zohráva zásadnú úlohu.
- Podmienky skladovania: Teplota chladničky a spôsob uskladnenia majú významný vplyv.
- Pridané ingrediencie: Ak sú cestoviny zmiešané s omáčkou alebo inými prísadami, môže sa ich trvanlivosť zmeniť.
Čerstvé vs. sušené cestoviny
Čerstvé cestoviny, často vyrábané z vajec a múky, majú kratšiu trvanlivosť ako sušené cestoviny. Vďaka vyššiemu obsahu vlhkosti sú náchylnejšie na rast baktérií. Čerstvé cestoviny by sa mali spotrebovať do 4-5 dní od uvarenia.
Sušené cestoviny, ktoré prešli procesom sušenia, majú oveľa dlhšiu trvanlivosť. Po uvarení a správnom uskladnení v chladničke vydržia približne 5-7 dní.
Spôsob prípravy a ochladzovania
Správna príprava cestovín je kľúčová pre ich trvanlivosť. Malo by sa postupovať nasledovne:
- Uvarte cestoviny podľa návodu: Nezabudnite ich variť "al dente", aby neboli príliš mäkké a kašovité.
- Rýchlo ochlaďte: Po uvarení cestoviny sceďte a prepláchnite studenou vodou, aby ste zastavili proces varenia a znížili teplotu. Tým sa spomalí rast baktérií.
- Odkvapkajte: Nechajte cestoviny dobre odkvapkať, aby ste sa zbavili prebytočnej vody.
Podmienky skladovania
Správne skladovanie je nevyhnutné pre zachovanie kvality a bezpečnosti cestovín:
- Utesnené nádoby: Cestoviny skladujte v vzduchotesnej nádobe, aby ste zabránili prístupu vzduchu a vlhkosti. Plastové nádoby s vekom alebo sklenené nádoby sú ideálne.
- Teplota chladničky: Udržujte teplotu chladničky na 4°C alebo nižšiu. Pravidelne kontrolujte, či vaša chladnička funguje správne.
- Oddelené skladovanie: Ak sú cestoviny zmiešané s omáčkou, skladujte ich oddelene od ostatných potravín, aby ste predišli kontaminácii.
Pridané ingrediencie a omáčky
Ak sú cestoviny zmiešané s omáčkou alebo inými prísadami, trvanlivosť sa môže líšiť:
- Omáčky na báze mliečnych výrobkov: Omáčky ako smotanová omáčka alebo syrová omáčka môžu skrátiť trvanlivosť cestovín. Mliečne výrobky sú náchylnejšie na rast baktérií, preto by sa takéto cestoviny mali spotrebovať do 2-3 dní.
- Omáčky na báze paradajok: Omáčky na báze paradajok, ako napríklad marinara, môžu predĺžiť trvanlivosť cestovín, pretože kyslosť paradajok môže inhibovať rast baktérií. Tieto cestoviny môžu vydržať 3-4 dni.
- Mäso a zelenina: Ak sú cestoviny zmiešané s mäsom alebo zeleninou, trvanlivosť sa riadi trvanlivosťou najrýchlejšie sa kaziacej zložky. Všeobecne platí, že takéto cestoviny by sa mali spotrebovať do 2-3 dní.
Uvarené cestoviny by sa mali spotrebovať maximálne do 3 - 4 dní za predpokladu, že boli uchovávané v chladničke. Je dôležité, aby ste ich neuchovávali na kuchynskej linke, ale aby ste ich po vychladnutí ihneď vložili do chladničky. V opačnom prípade sa môžu vyvinúť mikroorganizmy, ktoré sú škodlivé pre naše zdravie.
💡 5 tipov, ako správne skladovať potraviny v chladničke | Jednoduché tipy a triky | Lidl Slovensko
tags: #mozu #byt #cestoviny #pokazene
